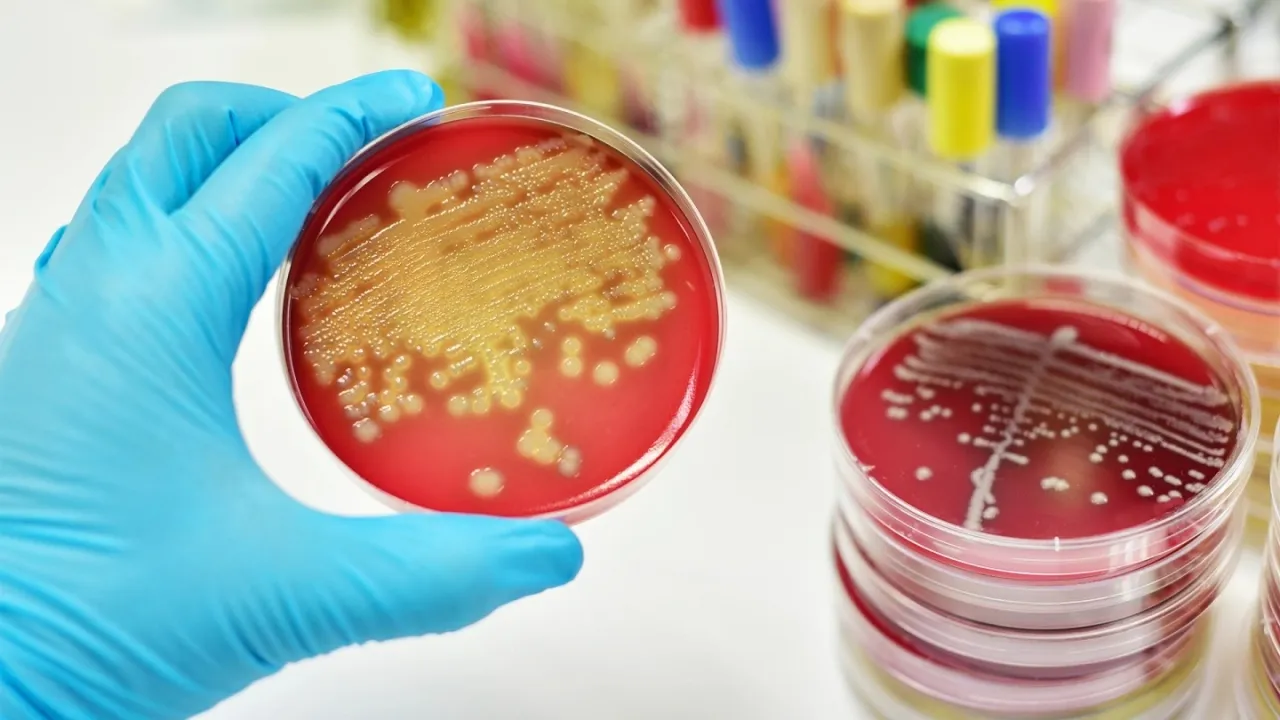

خبرني - قال تحالف سلامة المرضى بألمانيا إن تعفن الدم يمثل حالة طبية طارئة تستلزم استدعاء الإسعاف على وجه السرعة للخضوع للرعاية الطبية في الوقت المناسب، نظرا لأنه يهدد الحياة.
وأوضح التحالف أن تعفن الدم -المعروف أيضا باسم "تسمم الدم"- يحدث عندما يخرج جهاز المناعة في الجسم عن السيطرة، ويبدأ بمهاجمة أعضائه. وإذا ترك تعفن الدم دون علاج، فإنه يكون مميتا.
الأعراض :
وتتمثل الأعراض الدالة على الإصابة بتعفن الدم في:
• حالة الإعياء الشديدة
• الارتباك وفقدان التركيز
• ضيق التنفس وصعوبة التنفس وسرعة التنفس
• تسارع النبض وخفقان القلب
• انخفاض ضغط الدم
• الألم الشديد غير المبرر